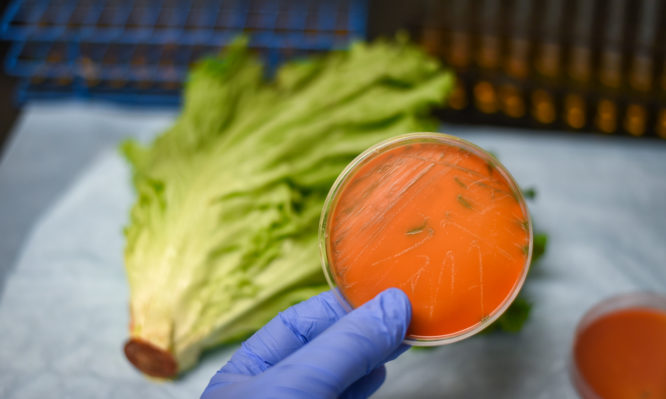

Λιστερίωση: Τα συμπτώματα της λοίμωξης από λιστέρια – Ποιες τροφές είναι πιο επικίνδυνες
Η λιστερίωση είναι πιο πιθανό να προσβάλλει έγκυες γυναίκες και νεογέννητα, ενήλικες ηλικίας 65 ετών και άνω και άτομα με εξασθενημένο ανοσοποιητικό σύστημα.
Ποιες τροφές είναι πιο πιθανό να σας προκαλέσουν λιστερίωση
Μη παστεριωμένο γάλα
Το ακατέργαστο είναι το γάλα από οποιοδήποτε ζώο που δεν έχει παστεριωθεί για να σκοτώσει τυχόν επιβλαβή βακτήρια. Το μη παστεριωμένο γάλα μπορεί να περιέχει βακτήρια, όπως η λιστέρια, που μπορεί να σας προκαλέσουν πολύ σοβαρές λοιμώξεις, ακόμα και θάνατο!
Παρόλο που είναι δυνατόν να πάθετε τροφική δηλητηρίαση από πολλά είδη τροφίμων, το μη παστεριωμένο γάλα είναι ένα από τα πιο επικίνδυνα.
Μαλακά τυριά
Τα μαλακά τυριά που παρασκευάζονται με μη παστεριωμένο γάλα εκτιμάται ότι είναι 50 έως 160 φορές πιο πιθανό να προκαλέσουν μόλυνση από λιστέρια, σε σχέση με όταν γίνονται με παστεριωμένο γάλα.
Παρόλο που η παστερίωση του γάλακτος σκοτώνει το βακτήριο λιστέρια, τα προϊόντα που παράγονται από παστεριωμένο γάλα είναι πιθανό να μολυνθούν με αυτό, αν παραχθούν σε εγκαταστάσεις με ανθυγιεινές συνθήκες.
Ωμές φύτρες λαχανικών
Οι φύτρες χρειάζονται ζεστές και υγρές συνθήκες για να αναπτυχθούν. Αυτές οι συνθήκες είναι επίσης ιδανικές για την ανάπτυξη βακτηριδίων, συμπεριλαμβανομένης της λιστέρια, της σαλμονέλας και του Ε. Coli.
Μην τρώτε ωμά ή ελαφρώς μαγειρεμένες φύτρες λαχανικών οποιουδήποτε είδους. Να μαγειρεύεται πάντοτε πολύ καλά τις φύτρες λαχανικών. Το να τις πλένετε απλώς καλά δεν θα απομακρύνει τα βακτήρια.
Πεπόνι
Το πεπόνι πρέπει να καταναλώνεται όσο το δυνατόν πιο σύντομα από την στιγμή που τεμαχίζεται. Πρέπει να διατηρείται σταθερά στο ψυγείο, αλλά όχι πάνω από μία εβδομάδα. Αν τεμαχισμένο πεπόνι έχει μείνει σε θερμοκρασία δωματίου (ειδικά το καλοκαίρι) για περισσότερες από 4 ώρες, πρέπει να το πετάξετε!
Αλλαντικά
Μην αφήνετε τους χυμούς από συσκευασμένα λουκάνικα και πακέτα από αλλαντικά να αγγίζουν άλλες τροφές, ή να παραμένουν σε επιφάνειες της κουζίνας. Να πλένετε τα χέρια σας αφότου χειρίζεστε τέτοια τρόφιμα.
Όταν ανοίγετε μια συσκευασία αλλαντικών, μην την κρατάτε στο ψυγείο για πάνω από μία εβδομάδα.
Καπνιστά ψάρια
Η κατανάλωση τόνου, σολομού και άλλων προϊόντων ψαριών σε κονσέρβες και σταθερούς σε ράφι δεν θεωρείται ότι αυξάνει την πιθανότητα να πάθετε λιστερίωση.
Είναι σημαντικό, όμως, να γνωρίζετε ότι δεν είναι όλα τα κονσερβοποιημένα τρόφιμα ασφαλή. Ορισμένα από αυτά φέρουν ένδειξη ότι πρέπει να διατηρούνται στο ψυγείο. Παραδείγματα τέτοιων ειδών περιλαμβάνουν τα καπνιστά θαλασσινά, όπως ο σολομός, η πέστροφα, ο μπακαλιάρος, ο τόνος και το σκουμπρί.
Λιστερίωση: Γενικά συμπτώματα
Εάν έχετε λιστερίωση, ενδέχεται να αντιμετωπίσετε:
- Πυρετό
- Μυϊκούς πόνους
- Ναυτία
- Διάρροια
Τα συμπτώματα μπορεί να αρχίσουν λίγες ημέρες αφότου έχετε φάει κάποια μολυσμένη τροφή, αλλά μπορεί να περάσουν μέχρι και δύο μήνες πριν από τα πρώτα συμπτώματα της λοίμωξης.
Αν η λιστερίωση εξαπλωθεί στο νευρικό σας σύστημα, τα συμπτώματα μπορεί να περιλαμβάνουν:
- Πονοκέφαλο
- Στραβολαίμιασμα
- Σύγχυση
- Απώλεια της ισορροπίας
- Σπασμούς
Λιστερίωση: Συμπτώματα για τις έγκυες και για τα νεογέννητα
Κατά τη διάρκεια της εγκυμοσύνης, η λιστερίωση είναι πιθανό να προκαλέσει μόνο ήπια συμπτώματα στην μητέρα. Οι συνέπειες για το μωρό, ωστόσο, μπορεί να είναι καταστροφικές. Το μωρό μπορεί να πεθάνει απροσδόκητα πριν από τη γέννησή του, ή να αντιμετωπίσει μια πολύ απειλητική για τη ζωή του λοίμωξη μέσα στις πρώτες λίγες ημέρες αφότου γεννηθεί.
Όπως και στους ενήλικες, τα συμπτώματα μιας λοίμωξης από λιστέρια σε ένα νεογέννητο μπορεί να είναι ήπια, αλλά θα περιλαμβάνουν:
- Μειωμένη όρεξη
- Ευερέθιστο μωρό, που “εκνευρίζεται” εύκολα
- Πυρετό
- Εμετό
Πότε πρέπει να δείτε ένα γιατρό
Εάν υποψιάζεστε ότι κάτι που φάγατε ήταν μολυσμένο και έχετε πυρετό, μυϊκούς πόνους, ναυτία ή διάρροια, επικοινωνήστε με το γιατρό σας.
Εάν αντιμετωπίζετε υψηλό πυρετό, έντονο πονοκέφαλο, δυσκαμψία του αυχένα, σύγχυση, ή ευαισθησία στο φως, ζητήστε επείγουσα ιατρική φροντίδα. Αυτά τα συμπτώματα μπορεί να υποδηλώνουν βακτηριακή μηνιγγίτιδα, μια απειλητική για τη ζωή επιπλοκή της λοίμωξης από λιστέρια.







